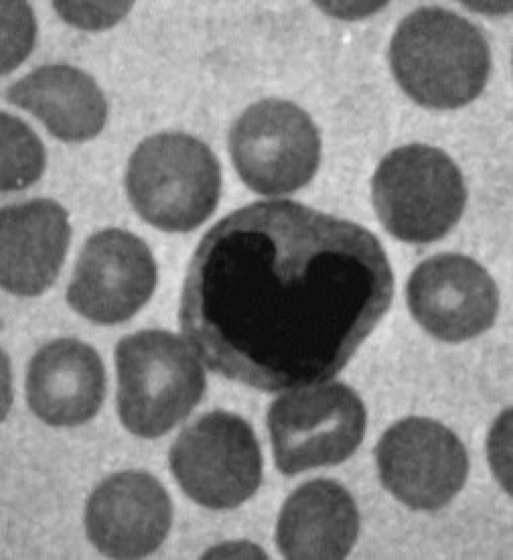

Redaktion
Dr. Hartwig Hanser, Waldkirch (Projektleitung)
Christine Scholtyssek (Assistenz)
Fachberater
Prof. Albert Ludolph, Ulm
Prof. Lothar Pickenhain, Leipzig
Prof. Heinrich Reichert, Basel
Prof. Manfred Spitzer, Ulm
Autoren
Aertsen, Prof., Ad, Freiburg
Aguzzi, Prof., Adriano, Zürich
Baier, Dr., Harmut, Ulm
Bartels, Prof., Mathias, Tübingen
Becker, Dr., Andreas, Marburg
Born, Prof., Jan, Lübeck
Brecht, Dr., Stephan, Kiel
Breer, Prof., Heinz, Stuttgart
Carenini, Dr., Stefano, Würzburg
Cruse, Prof., Holk, Bielefeld
Culmsee, Dr., Carsten, Marburg
Denzer, Dr., Alain, Waldenburg
Egert, Dr., Ulrich, Freiburg
Ehrenstein, Dr., Walter, Dortmund
Eurich, Dr., Christian , Bremen
Eysel, Prof., Ulf, Bochum
Fischbach, Prof., Karl-Friedrich, Freiburg
Frey, Dunja, Basel
Fuhr, Dr., Peter, Basel
Greenlee, Prof., Marc, Oldenburg
Hartmann, Beate, Basel
Heck, Dr., Detlef, Freiburg
Heller, Prof., Kurt, München
Henkel , Dr., Rolf , Bremen
Herdegen, Prof., Thomas, Kiel
Herrmann, Dr., Gudrun, Bern
Hilbig, Dr., Heidegard, Leipzig
Hirth, Dr., Frank, Basel
Huber, Dr., Gerhard, Zürich
Hund, Martin, Basel
Illing, Dr., Robert Benjamin, Freiburg
Käch, Dr., Stefanie, Basel
Kästler, Dr., Hans, Ulm
Kaiser, Dr., Reinhard, Freiburg
Kaluza, Jan, Stuttgart
Kapfhammer, Dr., Josef P., Freiburg
Kestler, Dr., Hans, Ulm
Kittmann, Dr., Rolf, Freiburg
Klix, Prof., Friedhart , Berlin
Klonk, Dr., Sabine, Stuttgart
Klumpp, Prof., Susanne, Marburg
Kössl, Dr., Manfred, München
Köster, Dr., Bernd, Freiburg
Kraetschmar, Dr., Gerhard, Ulm
Krieglstein, Prof., Josef, Marburg
Krieglstein, Prof., Kerstin, Homburg
Kuschinsky, Prof., Wolfgang, Heidelberg
Lahrtz, Stephanie, Hamburg
Landgraf, Dr., Uta, Stegen
Laux, Thorsten, Basel
Lindemann, Prof., Bernd, Homburg
Löffler, Dr., Sabine, Leipzig
Ludolph, Prof., Albert, Ulm
Malessa, Dr., Rolf, Weimar
Marksitzer, Dr., Rene, Luzern
Martin, Dr., Peter, Kehl-Kork
Martini, Prof., Rudolf, Würzburg
Medicus, Dr., Gerhard, Thaur
Mehraein, Dr., Susan, Freiburg
Meier, Dr., Kirstin, Freiburg
Mendelowitsch, Dr., Aminadav, Basel
Mergner, Prof., Thomas, Freiburg
Metzinger, Dr., Thomas, Frankfurt am Main
Mielke, Dr., Kirsten, Kiel
Misgeld, Prof., Ulrich, Heidelberg
Moll, Joachim, Basel
Münte, Prof., Thomas, Magdeburg
Neumann, Dr., Harald, Planegg-Martinsried
Nitsch, Prof., Cordula, Basel
Oehler, Prof., Jochen, Dresden
Otten, Prof., Uwe, Basel
Palm, Prof., Günther, Ulm
Pawelzik, Prof., Klaus, Bremen
Pickenhain, Prof., Lothar, Leipzig
Ravati, Alexander, Marburg
Reichel, Dr., Dirk, Lübeck
Reichert, Prof., Heinrich, Basel
Reinhard, Dr., Eva, Bern
Rieckmann, Dr., Peter, Würzburg
Riemann, Prof., Dieter, Freiburg
Ritter, Prof., Helge, Bielefeld
Roth, Prof., Gerhard , Bremen
Roth, Lukas W.A., Bern
Rotter, Dr., Stefan, Freiburg
Rubin, Dr., Beatrix, Basel
Ruth, Dr., Peter, Giessen
Schaller, Dr., Bernhard, Basel
Schedlowski, Prof., Manfred, Essen
Schneider, Dr., Werner X., München
Scholtyssek, Christine, Umkirch
Schwegler, Prof., Helmut , Bremen
Schwenker, Dr., Friedhelm, Ulm
Singer, Prof., Wolf, Frankfurt am Main
Spiegel, Dr., Roland, Zürich
Spitzer, Prof., Manfred, Ulm
Steck, Prof., Andreas, Basel
Steinlechner, Prof., Stephan, Hannover
Stephan, Dr., Achim, Rüsselsheim
Stoeckli, Dr., Esther, Basel
Stürzel, Frank, Freiburg
Swandulla, Prof., Dieter, Erlangen
Tolnay, Dr., Markus, Basel
Unsicker, Prof., Klaus, Heidelberg
Vaas, Rüdiger, Bietigheim-Bissingen
van Velthoven-Wurster, Dr., Vera, Freiburg
Walter, Dr., Henrik, Ulm
Wicht, Dr., Helmut, Frankfurt
Wolf, Prof., Gerald, Magdeburg
Wullimann, Prof., Mario, Bremen
Zeilhofer, Dr., Hans-Ulrich, Erlangen
Zimmermann, Prof., Manfred, Heidelberg
Wenn Sie inhaltliche Anmerkungen zu diesem Artikel haben, können Sie die Redaktion per E-Mail informieren. Wir lesen Ihre Zuschrift, bitten jedoch um Verständnis, dass wir nicht jede beantworten können.